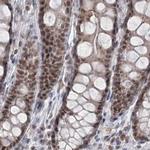
PDS5A Antibody in Immunohistochemistry (IHC)

Search
Invitrogen
PDS5A Polyclonal Antibody
{{$productOrderCtrl.translations['antibody.pdp.commerceCard.promotion.promotions']}}
{{$productOrderCtrl.translations['antibody.pdp.commerceCard.promotion.viewpromo']}}
{{$productOrderCtrl.translations['antibody.pdp.commerceCard.promotion.promocode']}}: {{promo.promoCode}} {{promo.promoTitle}} {{promo.promoDescription}}. {{$productOrderCtrl.translations['antibody.pdp.commerceCard.promotion.learnmore']}}
产品信息
PA5-57755
种属反应
宿主/亚型
分类
类型
抗原
偶联物
形式
浓度
规格
纯化类型
保存液
内含物
保存条件
运输条件
RRID
产品详细信息
Immunogen sequence: RSTGTETGSN INVNSELNPS TGNRSREQSS EAAETGVSEN EENPVRIISV TPVKNIDPVK NKEINSDQAT QGNISSDRGK KRTVTAA
Highest antigen sequence identity to the following orthologs: Mouse - 90%, Rat - 89%.
靶标信息
Nop56p is a yeast nucleolar protein that is part of a complex with the nucleolar proteins Nop58p and fibrillarin. Nop56p is required for assembly of the 60S ribosomal subunit and is involved in pre-rRNA processing. NOL5A is similar in sequence to Nop56p and is also found in the nucleolus. Multiple transcript variants encoding several different isoforms have been found for this gene, but the full-length nature of most of them have not been determined.Nop56p is a yeast nucleolar protein that is part of a complex with the nucleolar proteins Nop58p and fibrillarin. Nop56p is required for assembly of the 60S ribosomal subunit and is involved in pre-rRNA processing. The protein encoded by this gene is similar in sequence to Nop56p and is also found in the nucleolus. Multiple transcript variants encoding several different isoforms have been found for this gene, but the full-length nature of most of them have not been determined.
仅用于科研。不用于诊断过程。未经明确授权不得转售。
篇参考文献 (0)
生物信息学
蛋白别名: Cell proliferation-inducing gene 54 protein; PDS5, regulator of cohesion maintenance, homolog A; PIG54; SCC-112; Sister chromatid cohesion protein 112; Sister chromatid cohesion protein PDS5 homolog A; unnamed protein product
基因别名: KIAA0648; PDS5; PDS5A; PIG54; SCC-112; SCC112
UniProt ID: (Human) Q29RF7
Entrez Gene ID: (Human) 23244